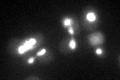
YCR020W-B
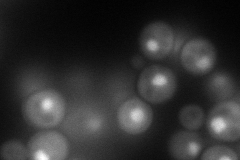
YCR020W-B
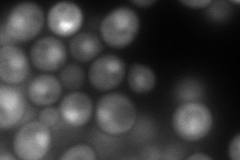
YCR020W-B
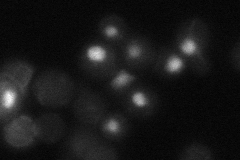
YCR020W-B

View description
Component of the RSC chromatin remodeling complex; RSC functions in transcriptional regulation and elongation, chromosome stability, and establishing sister chromatid cohesion; involved in telomere maintenance
Localization:
Intensity:
Fold change:
Significance:
-
C’ GFP library in SD
nucleus64.78 -
N' NOP1pr-GFP in SD
nucleus122.031 -
N' TEF2pr-mCherry in SD
nucleus168.613 -
N' NATIVEpr-GFP in SD
nucleus17.6526 -
N' TEF2pr-VC and Cyto-VN in SD

nucleus39.4689 -
C’ GFP library in SD+DTT

nucleus55.040.84No -
C’ GFP library in SD+H2O2

nucleus60.490.93No -
C’ GFP library in Starvation Media

nucleus58.10.89No -
C’ GFP library on the background of Pup2-DaMP

nucleus -
C’ GFP library on the background of CCT mutant

nucleus53.33950.823332No
